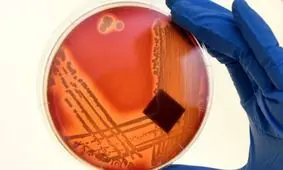
کشف آنتی‌بیوتیک‌های بسیار قوی با استفاده از هوش مصنوعی

آنتی بیوتیک
-

تاثیر شیرخام در حفظ باکتری های مقاوم به آنتی بیوتیک
یک مطالعه جدید نشان می دهد که گذاشتن شیر خام در دمای محیط می تواند ژن های ضدمیکروبی آن را آزاد کند.
-

داروهایی که شما را در برابر گرما آسیبپذیرتر میکند
بسیاری از داروها میتوانند آسیبپذیری بدن به گرما و نور خورشید را افزایش دهند و تاثیرات خود را به شکل بثورات پوستی، کم…
-

تصورات غلطی که درباره روشهای پیشگیری از کرونا وجود دارد
متخصص ویروس شناسی و عضو هیئت علمی دانشگاه علوم پزشکی البرز گفت: مصرف سیر و آنتی بیوتیک در پیشگیری از ابتلا به ویروس…
-

سازمان بهداشت جهانی هشدار داد؛
استفاده زیاد آنتی بیوتیکها باعث افزایش مرگومیر میشود
رئیس سازمان بهداشت جهانی روز گذشته در کنفرانس ویدئویی از ژنو اعلام کرد که استفاده بیش از حد از آنتیبیوتیکها برای…
-

تاثیر غیرقابل باور یک آنتی بیوتیک معمولی که همه در خانهها داریم ، بر درمان کرونا!
بهترین نقش درمانگری در بیماران در روزهای اخیر را داروی در دسترس آزیترو مایسین داشته است!
-

برای درمان بیماریهای ویروسی خودسرانه آنتیبیوتیک مصرف نکنید
یک متخصص بیماریهای عفونی، گفت: آنتیبیوتیکهایی که به طور معمول برای عفونتهای باکتریایی استفاده میشوند روی ویروسها…
-

چرا آنتیبیوتیک بر ویروس تاثیری ندارد؟
مصرف آنتیبیوتیکها تأثیری بر بهبود بیماریهای ویروسی ندارد زیرا این داروها تنها باکتری را مورد هدف قرار میدهند. اگر…
-

ویروس کرونا؛ با آنتی بیوتیک درمان میشود؟
ویروس جدید کرونا نوعی ویروس است پس نباید از آنتیبیوتیکها برای پیشگیری و درمان استفاده کرد.
-
کشف آنتیبیوتیکهای بسیار قوی با استفاده از هوش مصنوعی
پژوهشگران میگویند با استفاده از هوش مصنوع آنتیبیوتیکهایی بسیار قوی کشف کردهاند که میتوانند بر برخی از باکتریهای…
-

لزوم احتیاط در تجویز آنتیبیوتیک برای نوزادان
پزشکان در یک مطالعه تازه بار دیگر تاکید کردند که مصرف داروهای آنتی بیوتیک در دوران نوزادی ممکن است با افزایش خطر بروز…
